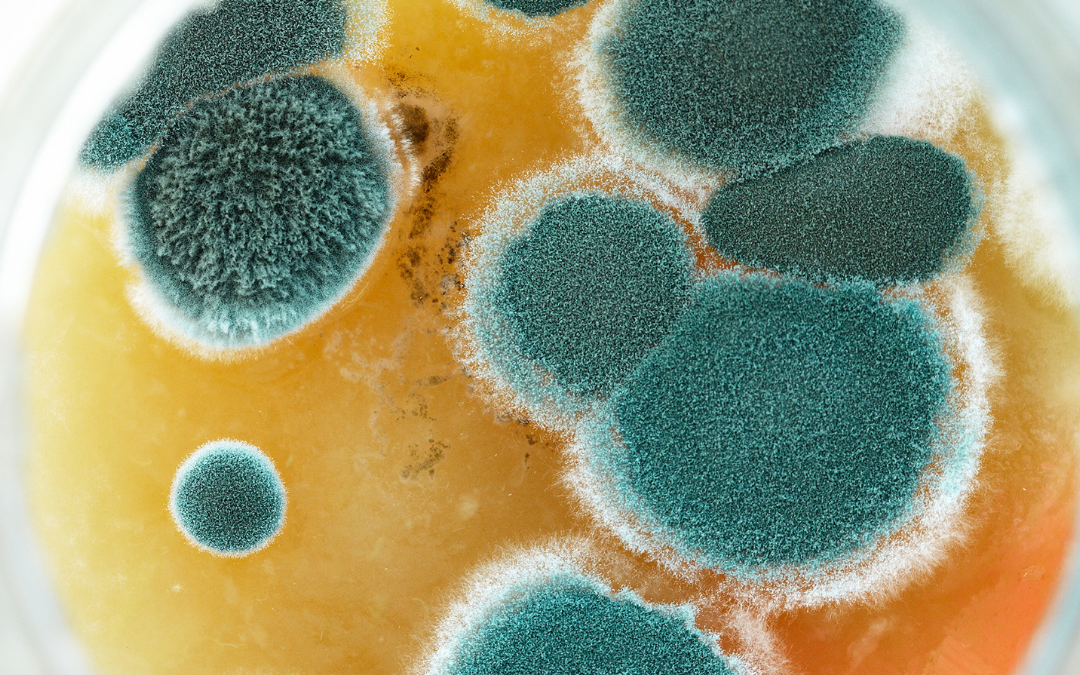
Holistic Approaches to Mold Remediation: Naturally Repairing Home and Body

Hurrah, you've reached a significant milestone in your baby's development! I'm so excited for you!!! That said, teething can be challenging for both the child and the parents because this process can start months before a tooth finally breaks free, causing discomfort,...